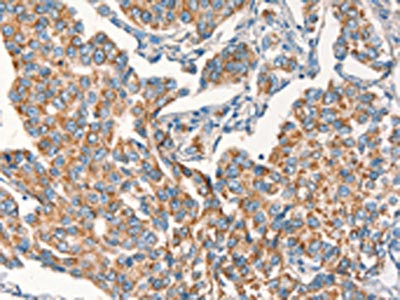

DSP Antibody
-
中文名稱:DSP兔多克隆抗體
-
貨號:CSB-PA093388
-
規格:¥1100
-
圖片:
-
The image on the left is immunohistochemistry of paraffin-embedded Human breast cancer tissue using CSB-PA093388(DSP Antibody) at dilution 1/15, on the right is treated with synthetic peptide. (Original magnification: ×200)
-
The image on the left is immunohistochemistry of paraffin-embedded Human brain tissue using CSB-PA093388(DSP Antibody) at dilution 1/15, on the right is treated with synthetic peptide. (Original magnification: ×200)
-
-
其他:
產品詳情
-
Uniprot No.:
-
基因名:DSP
-
別名:250/210 kDa paraneoplastic pemphigus antigen antibody; DCWHKTA antibody; Desmoplakin (DPI DPII) antibody; Desmoplakin antibody; Desmoplakin I antibody; Desmoplakin II antibody; DESP_HUMAN antibody; DP antibody; DP I antibody; DP II antibody; DPI antibody; DPII antibody; DSP antibody; KPPS2 antibody; PPKS 2 antibody; PPKS2 antibody
-
宿主:Rabbit
-
反應種屬:Human,Mouse
-
免疫原:Synthetic peptide of Human DSP
-
免疫原種屬:Homo sapiens (Human)
-
標記方式:Non-conjugated
-
抗體亞型:IgG
-
純化方式:Antigen affinity purification
-
濃度:It differs from different batches. Please contact us to confirm it.
-
保存緩沖液:-20°C, pH7.4 PBS, 0.05% NaN3, 40% Glycerol
-
產品提供形式:Liquid
-
應用范圍:ELISA,IHC
-
推薦稀釋比:
Application Recommended Dilution ELISA 1:1000-1:2000 IHC 1:25-1:100 -
Protocols:
-
儲存條件:Upon receipt, store at -20°C or -80°C. Avoid repeated freeze.
-
貨期:Basically, we can dispatch the products out in 1-3 working days after receiving your orders. Delivery time maybe differs from different purchasing way or location, please kindly consult your local distributors for specific delivery time.
-
用途:For Research Use Only. Not for use in diagnostic or therapeutic procedures.
相關產品
靶點詳情
-
功能:Major high molecular weight protein of desmosomes. Involved in the organization of the desmosomal cadherin-plakoglobin complexes into discrete plasma membrane domains and in the anchoring of intermediate filaments to the desmosomes.
-
基因功能參考文獻:
- This study provided evidence that rs2076304 in exon 15 of the DSP gene is associated with a significantly increased risk of silicosis in a Han Chinese population. PMID: 30207747
- For arrhythmogenic right ventricular cardiomyopathy patients, both missense and non-missense desmoplakin mutations carry a high arrhythmic risk. PMID: 28527814
- Using molecular dynamics simulations, study elucidated the structural basis of post-translational modifications-induced effects. Simulations, nearing 2 mus in aggregate, indicate that phosphorylation of S2849 induces an "arginine claw" in desmoplakin's C-terminal tail. PMID: 27188911
- Study identified DSP to be involved in the progressive intestinal injury associated with the development of Crohn's Disease complications via its effect on intestinal intercellular intermediate filament structure binding. PMID: 28490445
- report for the first time in Korea on monozygotic twins with lethal acantholytic epidermolysis bullosa caused by two novel nonsense mutations in the DSP gene PMID: 28442525
- Double heterozygotes for mutations in DSP and MYBPC3 showed a variable clinical presentation of arrhythmogenic cardiomyopathy and hypertrophic cardiomyopathy. PMID: 28699631
- Study reports a DSP mutation in an association with progressive cardiac conduction disease and a high risk of sudden death. The pathogenicity of the newly identified genetic variant was confirmed by in vitro prediction analysis and familial segregation. These results suggest that the effect of the mutation might be partially due to abnormal function of ion channels as a consequence of desmosomal remodeling. PMID: 27166992
- DSP is a desmosomal protein critical to cell-cell adhesion in a variety of cell types and important in wound healing and epithelial barrier function. PMID: 26669357
- Novel desmoplakin frameshift deletion p.Thr2625fs (c.7871_7872delAC) was identified as a potential cause of heart disease and sudden cardiac death in a Polish family. PMID: 27698334
- This is the first report of DSP genetic screening in Chinese sudden unexplained nocturnal death syndrome (SUNDS) and Brugada syndrome. Our results imply that DSP mutations contribute to the genetic cause of some SUNDS victims and maybe a new susceptible gene for Brugada syndrome. PMID: 26585738
- Syndrome featuring erythrokeratodermia and cardiomyopathy (EKC) caused by mutation in DSP was described. Specific region of DSP protein critical to the pathobiology of EKC syndrome and to DSP function in the heart and skin was identified. PMID: 26604139
- novel de novo heterozygous missense mutation caused severe dermatitis, multiple allergies, and metabolic wasting syndrome PMID: 26073755
- There is higher incidence of Myocarditis in DSP mutation carriers affected by Arrhythmogenic right ventricular dysplasia. PMID: 25616123
- Case Reports: desmoplakin mutations associated with variable woolly hair or hypotrichosis, palmoplantar keratoderma, and cardiac manifestations. PMID: 25227139
- Genetic testing revealed a novel combination of two heterozygous mutations in the DSP gene encoding desmoplakin PMID: 25516398
- Case Report: PKP2/DSP mutations in patient with Brugada syndrome and ventricular tachycardia. PMID: 25900994
- Patients whose MPM tissues expressed elevated mRNA levels of BIRC5, DSP, NME2, and THBS2 showed a statistically significant shorter overall survival. PMID: 25771974
- GSK3- and PRMT-1-dependent modifications of desmoplakin control desmoplakin-cytoskeleton dynamics. PMID: 25733715
- our data indicate that DP phosphorylation at S2849 represents an important mechanism in pemphigus pathogenesis PMID: 25010392
- a subset of arrhythmogenic cardiomyopathy mutations, in addition to a mutation associated with skin fragility/woolly hair syndrome, impair gap junction localization and function by misregulating DP-EB1 interactions and altering microtubule dynamics. PMID: 25225338
- Arrhythmogenic right ventricular cardiomyopathy patients of a three-generation Spanish family with a novel nonsense genetic variation in the DSP gene. PMID: 23954618
- The cardiomyopathy mechanisms varied accordingly to the specific types of DSP mutation identified and included haploinsufficiency, dominant-negative effects, or a combination hereof. PMID: 23137101
- DSP is inactivated in lung cancer by an epigenetic mechanism, increases the sensitivity to anticancer drug-induced apoptosis and has tumor-suppressive function, possibly through inhibition of the Wnt/beta-catenin signaling pathway in NSCLC cells. PMID: 22791817
- DSP splice variant is crucial for desmosome-mediated adhesion in HaCaT keratinocytes. PMID: 22454510
- In two unrelated patients with Naxos-Carvajal syndrome, a single heterozygous de novo mutation in the desmoplakin gene DSP, p.Leu583Pro and p.Thr564Ile, leading to severe phenotypes was found. PMID: 22949226
- Desmoplakin disease causes connexin mislocalization in the mouse & man preceding overt histological abnormalities resulting in significant alterations in conduction repolarization kinetics prior to morphological changes detectable on cardiac imaging PMID: 22240500
- Desmoplakin and pGSK3beta constitute independent good prognostic factors for progression free survival in Ewing Sarcoma patients. PMID: 22898789
- desmoplakin is a promising candidate for supportive CSF marker to rule out 14-3-3 false positive cases in sporadic Creutzfeldt-Jakob disease differential diagnosis. PMID: 22213780
- desmoplakin I levels, determined within 1-3 months of the first ischemic stroke, could be a biomarker for statin responsiveness against a new vascular event in post-ischemic stroke patients taking statins PMID: 22304020
- Palmitate significantly reduces DSP expression, and treatment with insulin restores the lost expression of DSP. PMID: 22132232
- Case Report: desmoplakin mutation responsible for juvenile biventricular cardiomyopathy with left ventricular non-compaction and acantholytic palmoplantar keratoderma. PMID: 21789513
- DP Ser2849Gly promotes hyperadhesion PMID: 21993560
- We detected a novel mutations: DSP T1373A and it may be associated with a risk for tachycardia PMID: 21397041
- A novel nonsense mutation in the desmoplakin gene and the truncated protein which it produces caused left dominant arrhythmogenic cardiomyopathy PMID: 21458130
- Mutations in desmoplakin protein is associated with cardiomyopathy. PMID: 21756917
- Full sequencing of the DSP showed a novel homozygous c.7097 G>A (p.R2366H) mutation in all skin fragility-woolly hair syndrome affected family members. PMID: 20738328
- intimate intramolecular association of the SH3 domain with the preceding SR is also observed in plectin, another plakin protein suggesting that the SH3 domain of plakins contributes to the stability and rigidity of this subfamily of SR-containing proteins PMID: 21536047
- SERCA2-deficient cells exhibited up to a 60% reduction in border translocation of desmoplakin (DP), the desmosomal cytolinker protein necessary for intermediate filament (IF) anchorage to sites of robust cell-cell adhesion PMID: 21156808
- autosomal-dominant mutations in the DSP gene are associated with hypo/oligodontia in the setting of Carvajal/Naxos syndrome PMID: 20940358
- A novel minor isoform of desmoplakin that is also produced by alternative splicing of the desmoplakin gene, is described. PMID: 20524011
- we describe a combination of DP mutation phenotypes affecting the skin, heart, hair, and teeth PMID: 19924139
- Lethal acantholytic epidermolysis bullosa (LAEB) is an autosomal recessive disorder caused by mutations in the gene encoding the desmosomal protein, desmoplakin (DSP) PMID: 19945626
- Compound heterozygosity for non-sense and mis-sense mutations in desmoplakin underlies skin fragility/woolly hair syndrome. haploinsufficiency PMID: 11841538
- non-small cell lung carcinoma subtypes have specific patterns of desmoplakin 1 and 2 and cytokeratin 18 gene expression, protein content and biodistribution PMID: 11955647
- Mutation (S299R) in exon 7 of desmoplakin causes arrhythmogenic right ventricular cardiomyopathy, unlinked to other causes. PMID: 12373648
- desmoplakin has a role in capillary formation PMID: 15190119
- Naxos disease is not caused by the desmoplakin gene mutation in an arab family. PMID: 15494820
- the involvement of desmoplakin (DP), plectin, and periplakin in the destruction of epithelial cell integrity ensures the efficient elimination of cytoskeleton, but also provides specificity for selectively targeting individual adhesion molecules PMID: 15500642
- dominant mutation in desmoplakin that causes left-sided arrhythmogenic left ventricular cardiomyopathywith arrhythmias of left ventricular origin. PMID: 16061754
- dramatic phenotype, which we named "lethal acantholytic epidermolysis bullosa," underscores the paramount role of desmoplakin in epidermal integrity PMID: 16175511
顯示更多
收起更多
-
相關疾病:Keratoderma, palmoplantar, striate 2 (SPPK2); Cardiomyopathy, dilated, with woolly hair and keratoderma (DCWHK); Arrhythmogenic right ventricular dysplasia, familial, 8 (ARVD8); Skin fragility-woolly hair syndrome (SFWHS); Epidermolysis bullosa, lethal acantholytic (EBLA); Cardiomyopathy, dilated, with woolly hair, keratoderma, and tooth agenesis (DCWHKTA)
-
亞細胞定位:Cell junction, desmosome. Cytoplasm, cytoskeleton. Cell membrane.
-
蛋白家族:Plakin or cytolinker family
-
組織特異性:Isoform DPI is apparently an obligate constituent of all desmosomes. Isoform DPII resides predominantly in tissues and cells of stratified origin.
-
數據庫鏈接:
Most popular with customers
-
-
YWHAB Recombinant Monoclonal Antibody
Applications: ELISA, WB, IHC, IF, FC
Species Reactivity: Human, Mouse, Rat
-
Phospho-YAP1 (S127) Recombinant Monoclonal Antibody
Applications: ELISA, WB, IHC
Species Reactivity: Human
-
-
-
-
-